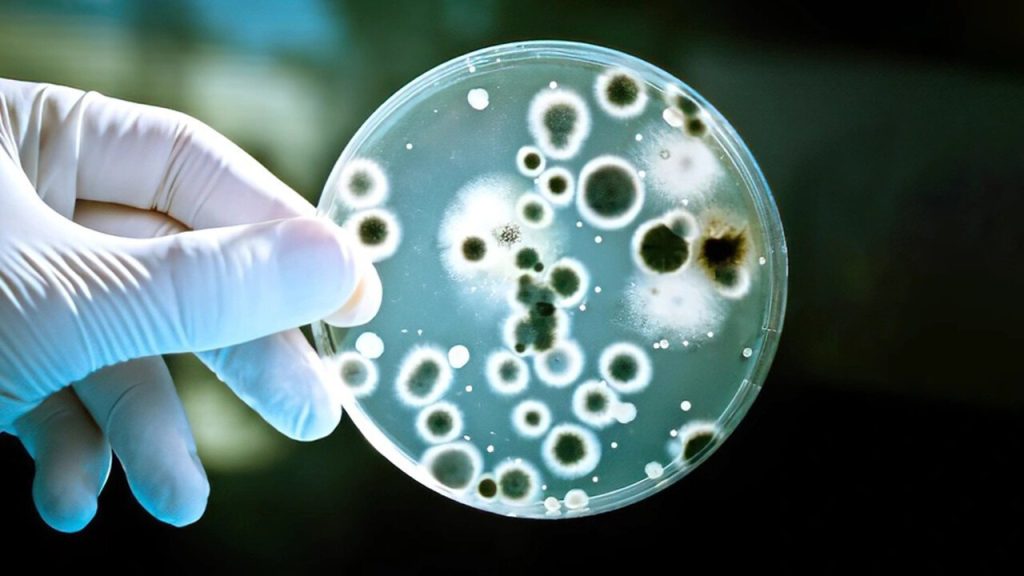
Bilim insanları mevcut ilaçlardan 100 kat güçlü antibiyotik keşfetti

Live Science’ın aktardığı habere göre bilim insanları, antibiyotik direncine karşı mücadelede çığır açabilecek yeni bir bileşik keşfetti. Pre-methylenomycin C lactone adı verilen bu yeni madde, özellikle MRSA ve Enterococcus faecium gibi antibiyotiklere dirençli “süperbakterilere” karşı olağanüstü seviyede etkili bulundu. Çalışma, Journal of the American Chemical Society dergisinde yayımlandı.
İngiltere’den Lona Alkhalaf ve Greg Challis liderliğindeki araştırma ekibi, toprakta yaşayan Streptomyces coelicolor bakterisinin bilinen antibiyotiklerden methylenomycin A’yı nasıl ürettiğini inceliyordu. Bu süreçte iki yeni molekül fark edildi ve bunlardan biri beklentileri aşan güçlü bir antibiyotik etki gösterdi. Araştırmacılara göre keşfedilen madde, tamamen yeni bir antibiyotik sınıfının ilk örneği olarak değerlendiriliyor.
Laboratuvar testlerinde yeni bileşiğin dirençli bakterileri öldürmede bilinen antibiyotikten 100 kat daha güçlü olduğu tespit edildi.
Çalışmanın en dikkat çekici bulgularından biri de bileşiğin direnç geliştirmemesiydi. 28 gün süren deneylerde bakteriler sürekli ilaca maruz bırakılmasına rağmen hiçbir direnç mekanizması oluşmadı. Bu sonuç, antibiyotik direncinin küresel ölçekte büyüyen bir tehdit olduğu günümüzde bilim dünyasında önemli bir umut olarak değerlendiriliyor.
Queen’s University Belfast’tan kimyager Stephen Cochrane, keşfin heyecan verici olduğunu ancak laboratuvar sonuçlarının klinik tedavilere dönüşmesinin her zaman uzun ve zorlu bir süreç gerektirdiğini hatırlatıyor. Uzmanlara göre toksisite, güvenlik, dozlama ve insan vücudundaki davranış gibi aşamaların ayrıntılı şekilde incelenmesi gerekiyor.
Araştırma ekibi, artık bileşiğin yapay üretimi üzerinde çalışıyor. Bu amaçla Avustralya’daki Monash Üniversitesi’nden kimyager David Lupton ile ortak bir proje yürütülüyor. Yapay sentez sayesinde maddenin daha büyük miktarlarda üretilmesi ve geniş kapsamlı testlere tabi tutulması planlanıyor.
Bilim insanları bundan sonraki aşamada bileşiğin bakteri hücrelerinde nasıl etki gösterdiğini anlamayı ve daha güçlü versiyonlarını geliştirmeyi hedefliyor.